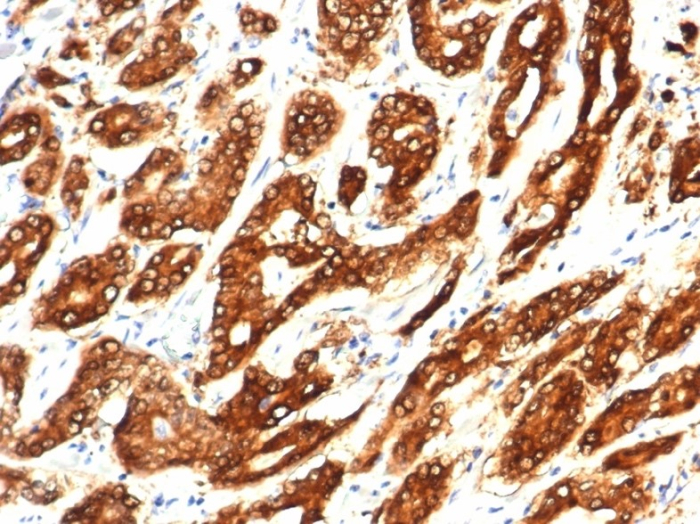
Isocitrate Dehydrogenase 1/IDH1 Antibody (IDH1.R132H/7277R)

391 results for "Isocitrate Dehydrogenase 1/IDH1 Primary Antibodies" in Products
Isocitrate Dehydrogenase 1/IDH1: Antibodies
R&D Systems offers high quality Isocitrate Dehydrogenase 1/IDH1 antibodies from R&D Systems, and Novus Biologicals brands. Our Isocitrate Dehydrogenase 1/IDH1 antibodies have been validated in multiple research applications, including Knockout Validated, Immunohistochemistry, Western Blot, ELISA, Flow Cytometry, and more. These antibodies are reactive in Human, Mouse, Rat, Canine, and Monkey. Our catalog includes anti-Isocitrate Dehydrogenase 1/IDH1 monoclonal, polyclonal, and recombinant ...
Recombinant Monoclonal Antibody
| Reactivity: | Human |
| Details: | Rabbit IgG Kappa Monoclonal Clone #IDH1.R132H/8205R |
| Applications: | IHC |
Recombinant Monoclonal Antibody
| Reactivity: | Human |
| Details: | Rabbit IgG Kappa Monoclonal Clone #IDH1.R132H/7328R |
| Applications: | IHC |
| Reactivity: | Human |
| Details: | Mouse IgG1 kappa Monoclonal Clone #IDH1/1152 |
| Applications: | IHC, ICC/IF |
Recombinant Monoclonal Antibody
| Reactivity: | Human |
| Details: | Rabbit IgG Kappa Monoclonal Clone #IDH1.R132H/7277R |
| Applications: | IHC |
Recombinant Monoclonal Antibody
| Reactivity: | Human |
| Details: | Rabbit IgG Kappa Monoclonal Clone #IDH1/6806R |
| Applications: | IHC |
| Reactivity: | Human |
| Details: | Mouse IgG1 kappa Monoclonal Clone #IDH1/1152 |
| Applications: | IHC, WB, ICC/IF, Flow |
| Reactivity: | Human |
| Details: | Mouse IgG1 kappa Monoclonal Clone #IDH1/1152 |
| Applications: | IHC, ICC/IF |
| Reactivity: | Human |
| Details: | Mouse IgG1 kappa Monoclonal Clone #IDH1/1152 |
| Applications: | IHC |
Recombinant Monoclonal Antibody
| Reactivity: | Human |
| Details: | Rabbit IgG Kappa Monoclonal Clone #IDH1/6806R |
| Applications: | IHC |
Recombinant Monoclonal Antibody
| Reactivity: | Human |
| Details: | Rabbit IgG Kappa Monoclonal Clone #IDH1.R132H/7277R |
| Applications: | IHC |
Recombinant Monoclonal Antibody
| Reactivity: | Human |
| Details: | Rabbit IgG Kappa Monoclonal Clone #IDH1.R132H/7277R |
| Applications: | IHC |
Recombinant Monoclonal Antibody
| Reactivity: | Human |
| Details: | Rabbit IgG Kappa Monoclonal Clone #IDH1.R132H/7328R |
| Applications: | IHC |
Recombinant Monoclonal Antibody
| Reactivity: | Human |
| Details: | Rabbit IgG Kappa Monoclonal Clone #IDH1.R132H/7328R |
| Applications: | IHC |
Recombinant Monoclonal Antibody
| Reactivity: | Human |
| Details: | Rabbit IgG Kappa Monoclonal Clone #IDH1/6806R |
| Applications: | IHC |
Recombinant Monoclonal Antibody
| Reactivity: | Human |
| Details: | Rabbit IgG Kappa Monoclonal Clone #IDH1.R132H/8205R |
| Applications: | IHC |
Recombinant Monoclonal Antibody
| Reactivity: | Human |
| Details: | Rabbit IgG Kappa Monoclonal Clone #IDH1.R132H/8205R |
| Applications: | IHC |
Recombinant Monoclonal Antibody
| Reactivity: | Human |
| Details: | Rabbit IgG Kappa Monoclonal Clone #IDH1.R132H/7277R |
| Applications: | IHC |
Recombinant Monoclonal Antibody
| Reactivity: | Human |
| Details: | Rabbit IgG Kappa Monoclonal Clone #IDH1.R132H/7277R |
| Applications: | IHC |
Recombinant Monoclonal Antibody
| Reactivity: | Human |
| Details: | Rabbit IgG Kappa Monoclonal Clone #IDH1.R132H/7277R |
| Applications: | IHC |
Recombinant Monoclonal Antibody
| Reactivity: | Human |
| Details: | Rabbit IgG Kappa Monoclonal Clone #IDH1.R132H/7277R |
| Applications: | IHC |
Recombinant Monoclonal Antibody
| Reactivity: | Human |
| Details: | Rabbit IgG Kappa Monoclonal Clone #IDH1.R132H/7277R |
| Applications: | IHC |
Recombinant Monoclonal Antibody
| Reactivity: | Human |
| Details: | Rabbit IgG Kappa Monoclonal Clone #IDH1.R132G/13054R |
| Applications: | IHC |
Recombinant Monoclonal Antibody
| Reactivity: | Human |
| Details: | Rabbit IgG Kappa Monoclonal Clone #IDH1.R132G/13054R |
| Applications: | IHC |
Recombinant Monoclonal Antibody
| Reactivity: | Human |
| Details: | Rabbit IgG Kappa Monoclonal Clone #IDH1.R132H/8205R |
| Applications: | IHC |
Recombinant Monoclonal Antibody
| Reactivity: | Human |
| Details: | Rabbit IgG Kappa Monoclonal Clone #IDH1.R132H/8205R |
| Applications: | IHC |

![Product Feature: CoraFluor Probes for TR-FRET Isocitrate Dehydrogenase 1/IDH1 Antibody (IDH1.R132H/8205R) [CoraFluor™ 1]](https://resources.bio-techne.com/images/products/nbp3-20990cl1_rabbit-idh1-mab-idh1-r132h-8205r-cl1-129202514582014.png)
![Product Feature: CoraFluor Probes for TR-FRET Isocitrate Dehydrogenase 1/IDH1 Antibody (IDH1.R132H/7328R) [CoraFluor™ 1]](https://resources.bio-techne.com/images/products/nbp3-20989cl1_rabbit-idh1-mab-idh1-r132h-7328r-cl1-12920251584021.png)
![Product Feature: CoraFluor Probes for TR-FRET Isocitrate Dehydrogenase 1/IDH1 Antibody (IDH1/1152) [CoraFluor™ 1]](https://resources.bio-techne.com/images/products/nbp2-47744cl1_mouse-isocitrate-dehydrogenase-1-idh1-mab-idh1-1152-cl1-81020251135521.png)
![Product Feature: CoraFluor Probes for TR-FRET Isocitrate Dehydrogenase 1/IDH1 Antibody (IDH1.R132H/7277R) [CoraFluor™ 1]](https://resources.bio-techne.com/images/products/nbp3-20986cl1_rabbit-idh1-mab-idh1-r132h-7277r-cl1-12920251458208.png)
![Product Feature: CoraFluor Probes for TR-FRET Isocitrate Dehydrogenase 1/IDH1 Antibody (IDH1/6806R) [CoraFluor™ 1]](https://resources.bio-techne.com/images/products/nbp3-14080cl1_rabbit-idh1-mab-idh1-6806r-cl1-29920251522545.png)
![Immunocytochemistry/ Immunofluorescence: Isocitrate Dehydrogenase 1/IDH1 Antibody (IDH1/1152) [NBP2-45156] Immunocytochemistry/ Immunofluorescence: Isocitrate Dehydrogenase 1/IDH1 Antibody (IDH1/1152) [NBP2-45156]](https://resources.bio-techne.com/images/products/Isocitrate-Dehydrogenase-1-IDH1-Antibody-IDH1-1152-Immunocytochemistry-Immunofluorescence-NBP2-45156-img0004.jpg)
![Immunocytochemistry/ Immunofluorescence: Isocitrate Dehydrogenase 1/IDH1 Antibody (IDH1/1152) - Azide and BSA Free [NBP2-47744] Immunocytochemistry/ Immunofluorescence: Isocitrate Dehydrogenase 1/IDH1 Antibody (IDH1/1152) - Azide and BSA Free [NBP2-47744]](https://resources.bio-techne.com/images/products/Isocitrate-Dehydrogenase-1-IDH1-Antibody-IDH1-1152-Azide-and-BSA-Free-Immunocytochemistry-Immunofluorescence-NBP2-47744-img0004.jpg)
![Immunohistochemistry-Paraffin: Isocitrate Dehydrogenase 1/IDH1 Antibody (IDH1/1152) - IHC-Prediluted [NBP2-48302] Immunohistochemistry-Paraffin: Isocitrate Dehydrogenase 1/IDH1 Antibody (IDH1/1152) - IHC-Prediluted [NBP2-48302]](https://resources.bio-techne.com/images/products/Isocitrate-Dehydrogenase-1-IDH1-Antibody-IDH1-1152-IHC-Prediluted-Immunohistochemistry-Paraffin-NBP2-48302-img0003.jpg)
![Immunohistochemistry-Paraffin: Isocitrate Dehydrogenase 1/IDH1 Antibody (IDH1/6806R) [NBP3-13943] Immunohistochemistry-Paraffin: Isocitrate Dehydrogenase 1/IDH1 Antibody (IDH1/6806R) [NBP3-13943]](https://resources.bio-techne.com/images/products/Isocitrate-Dehydrogenase-1-IDH1-Antibody-IDH1-6806R-Immunohistochemistry-Paraffin-NBP3-13943-img0002.jpg)

![Immunohistochemistry-Paraffin: Isocitrate Dehydrogenase 1/IDH1 Antibody (IDH1.R132G/13054R) [NBP3-49138] - Isocitrate Dehydrogenase 1/IDH1 Antibody (IDH1.R132G/13054R)](https://resources.bio-techne.com/images/products/nbp3-49138_rabbit-idh1-mab-idh1-r132g-13054r-immunohistochemistry-paraffin-141120251447411.jpg)
![Immunohistochemistry-Paraffin: Isocitrate Dehydrogenase 1/IDH1 Antibody (IDH1.R132G/13054R) - Azide and BSA Free [NBP3-49672] - Isocitrate Dehydrogenase 1/IDH1 Antibody (IDH1.R132G/13054R) - Azide and BSA Free](https://resources.bio-techne.com/images/products/nbp3-49672_rb-idh1-mab-idh1-r132g-13054r-azide-bsa-free-immunohistochemistry-paraffin-1411202516372216.jpg)
